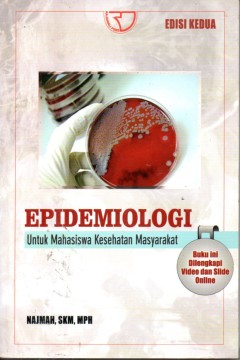
cover

Ditapis dengan
Ditemukan 2 dari pencarian Anda melalui kata kunci: author=NAJMAH

Epidemiologi Untuk Mahasiswa Kesehatan Masyarakat
- Edisi
- -
- ISBN/ISSN
- 978-602-425-052-2
- Deskripsi Fisik
- 246 hlm, 15,5 x 23 cm
- Judul Seri
- -
- No. Panggil
- 614.4 NAJ e
- Edisi
- -
- ISBN/ISSN
- 978-602-425-052-2
- Deskripsi Fisik
- 246 hlm, 15,5 x 23 cm
- Judul Seri
- -
- No. Panggil
- 614.4 NAJ e
Epidemiologi Penyakit Menular
- Edisi
- -
- ISBN/ISSN
- 978-602-202-187-2
- Deskripsi Fisik
- xxvi, 300 hlm, 14 x 21 cm
- Judul Seri
- -
- No. Panggil
- 614 NAJ e
- Edisi
- -
- ISBN/ISSN
- 978-602-202-187-2
- Deskripsi Fisik
- xxvi, 300 hlm, 14 x 21 cm
- Judul Seri
- -
- No. Panggil
- 614 NAJ e
 Karya Umum
Karya Umum  Filsafat
Filsafat  Agama
Agama  Ilmu-ilmu Sosial
Ilmu-ilmu Sosial  Bahasa
Bahasa  Ilmu-ilmu Murni
Ilmu-ilmu Murni  Ilmu-ilmu Terapan
Ilmu-ilmu Terapan  Kesenian, Hiburan, dan Olahraga
Kesenian, Hiburan, dan Olahraga  Kesusastraan
Kesusastraan  Geografi dan Sejarah
Geografi dan Sejarah